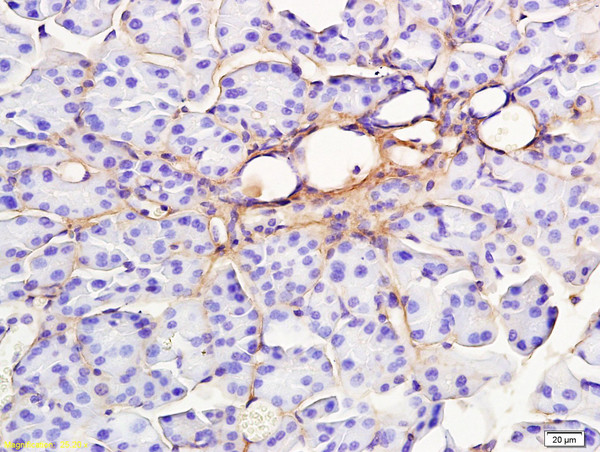
RAP1GAP Antibody in Immunohistochemistry (Paraffin) (IHC (P))

Search
Bioss
RAP1GAP Polyclonal Antibody
{{$productOrderCtrl.translations['antibody.pdp.commerceCard.promotion.promotions']}}
{{$productOrderCtrl.translations['antibody.pdp.commerceCard.promotion.viewpromo']}}
{{$productOrderCtrl.translations['antibody.pdp.commerceCard.promotion.promocode']}}: {{promo.promoCode}} {{promo.promoTitle}} {{promo.promoDescription}}. {{$productOrderCtrl.translations['antibody.pdp.commerceCard.promotion.learnmore']}}
产品信息
BS-2918R
种属反应
宿主/亚型
分类
类型
抗原
偶联物
形式
浓度
规格
纯化类型
保存液
内含物
保存条件
运输条件
靶标信息
Rap1GAP specifically stimulates GTP hydrolytic activity of the monomeric G protein Rap1. Physical interaction between G alpha z, a member of the Gi family of trimeric G proteins, and Rap1GAP blocks the ability of regulators of G protein signaling to stimulate GTP hydrolysis of the alpha subunit, and also attenuates the ability of activated G alpha z to inhibit adenylyl cyclase. Rap1GAP is expressed in the brain, kidney and pancreas and may act as a signal integrator to coordinate and/or integrate Gz signaling and Rap1 signaling in cells. A novel isoform of Rapl GTPase-activating protein, designated Rap1GAPII, binds specifically to G alpha z. Stimulation of the Gi-coupled M2 Muscarinic receptor translocates Rap1GAPII from the cytosol to the membrane and decreases the amount of GTP-bound Rap1, resulting in the activation of ERK/MAPK.
仅用于科研。不用于诊断过程。未经明确授权不得转售。
篇参考文献 (0)
生物信息学
蛋白别名: ARPP-90; Rap1 GTPase-activating protein 1; Rap1, GTPase-activating protein 1; Rap1GAP
基因别名: 1300019I11Rik; 2310004O14Rik; AI427470; ARPP-90; KIAA0474; RAP1GA1; RAP1GAP; RAP1GAP1; RAP1GAPII; RAPGAP
UniProt ID: (Human) P47736, (Mouse) A2ALS5
Entrez Gene ID: (Human) 5909, (Mouse) 110351, (Rat) 313644